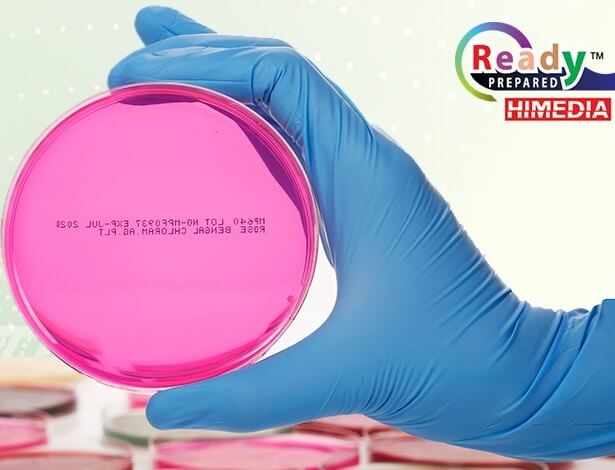

蛋黃液100ML | Egg Yolk Tellurite Emulsion HIMEDIA貨號FD046
| 代理廠牌: | |
| 原廠連結: | |
| 相關下載: |
特點

Egg Yolk Tellurite Emulsion (50 ml/100 ml per vial) HIMEDIA貨號FD046
產品介紹:
Egg Yolk Tel Emulsion (100 ml )蛋黃液 (貨號:FD046)
建議用於 Baird Parker 培養基中用於鑑定葡萄球菌。 蛋黃亞碲酸鹽乳劑 (Egg Yolk Tellurite Emulsion), 是用於微生物學的穩定蛋黃乳劑,可直接添加到營養培養基( nutrient media)中,用於通過卵磷脂酶活性(lecithinase activity)鑑定凝固酶陽性葡萄球菌菌株(coagulase-positive Staphylococci )。冷藏的蛋黃碲酸鹽乳液加熱至 40-45°C。充分搖勻以獲得均勻的乳液(因為冷藏乳液容易形成層或小塊)。Egg-yolk tellurite emulsion is a stabilized emulsion of egg yolk for microbiological use, which is added directly to nutrient media for the identification of strains of coagulase-positive Staphylococci by their lecithinase activity.
